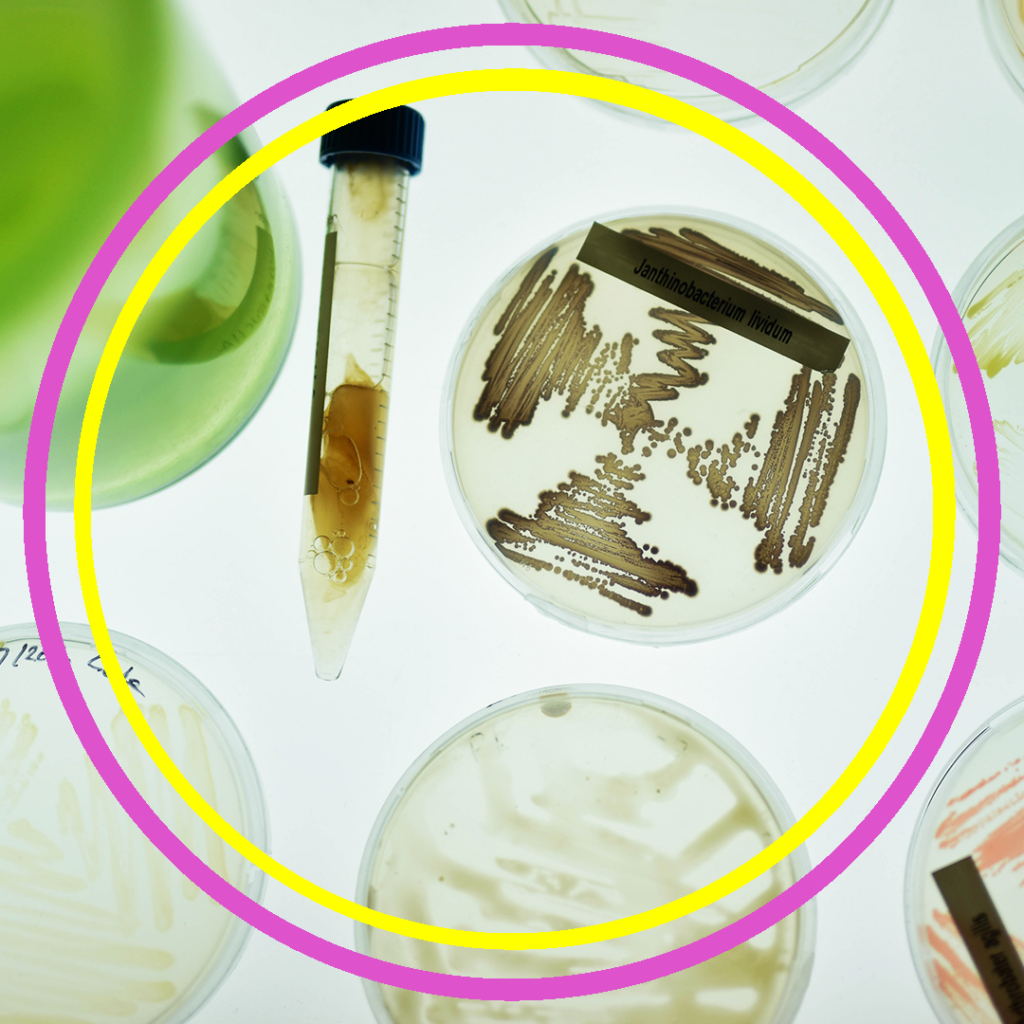

Logo and visual identity for an art project were natural dyes were extracted from plants grown in public parks and gardens. The dyes were eventually used to color a jacket for the mayor of Amsterdam.








Logo and visual identity for an art project were natural dyes were extracted from plants grown in public parks and gardens. The dyes were eventually used to color a jacket for the mayor of Amsterdam.